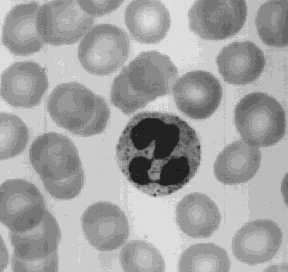

Blood
 Blood is a liquid tissue. Suspended in the watery plasma are seven types of cells and cell fragments.
Blood is a liquid tissue. Suspended in the watery plasma are seven types of cells and cell fragments.
- red blood cells (RBCs) or erythrocytes
- platelets or thrombocytes
- five kinds of white blood cells (WBCs) or leukocytes
- Three kinds of granulocytes
- Two kinds of leukocytes without granules in their cytoplasm
If one takes a sample of blood, treats it with an agent to prevent clotting, and spins it in a centrifuge,
- the red cells settle to the bottom
- the white cells settle on top of them forming the "buffy coat".
The fraction occupied by the red cells is called the hematocrit. Normally it is approximately 45%. Values much lower than this are a sign of anemia. |
Functions of the blood
Blood performs two major functions:
- transport through the body of
- oxygen and carbon dioxide
- food molecules (glucose, lipids, amino acids)
- ions (e.g., Na+, Ca2+, HCO3-)
- wastes (e.g., urea)
- hormones
- heat
- defense of the body against infections and other foreign materials. All the WBCs participate in these defenses.
The formation of blood cells (cell types and acronyms are defined below)
All the various types of blood cells
- are produced in the bone marrow (some 1011 of them each day in an adult human!).
- arise from a single type of cell called a pluripotent stem cell.
These stem cells
- are very rare (only about one in 10,000 bone marrow cells)
- express a surface protein designated CD34
- produce, by mitosis, two kinds of progeny
- more stem cells
- cells that begin to differentiate along the paths leading to the various kinds of blood cells.
Which path is taken is regulated by
- the need for more of that type of blood cell which is, in turn, controlled by appropriate cytokines and/or hormones.
Examples:
- red blood cells. Oxygen shortage (such as found at high altitude) stimulates the kidney to release erythropoietin (EPO) which enhances the production of RBCs.
- platelets. The hormone thrombopoietin (TPO, secreted by the liver), assisted by Interleukin-6 (IL-6), stimulates the production of megakaryocytes and their fragmentation into platelets.
- Interleukin-7 (IL-7) is a major factor in stimulating bone marrow cells to start down the path leading to the various lymphocytes (mostly B cells and T cells).
- Interleukin-5 (IL-5) is a major cytokine leading to the formation of eosinophils.
- Interleukin-3 (IL-3) participates in the differentiation of most of the white blood cells but plays a particularly prominent role in the formation of basophils (responsible for some allergies).
- Granulocyte-monocyte colony-stimulating factor (GM-CSF), as its name suggests, sends cells down the path leading to both those cell types. In due course, one path or the other is taken.
- Under the influence of granulocyte colony-stimulating factor (G-CSF), they differentiate into neutrophils.
- Stimulated by macrophage colony-stimulating factor (M-CSF) they differentiate into monocytes, the precursors of macrophages.
Red Blood Cells (erythrocytes)
 The most numerous type in the blood.
The most numerous type in the blood.
- Women average about 4.8 million of these cells per cubic millimeter (mm3; which is the same as a microliter [µl]) of blood
- Men average about 5.4 x 106 per µl
- These values can vary over quite a range depending on such factors as health, and altitude. (Peruvians living at 18,000 feet may have as many as 8.3 x 106 RBCs per µl.)
As RBC precursors mature in the bone marrow,
- they manufacture hemoglobin until it accounts for some 90% of the dry weight of the cell
- the nucleus is squeezed out of the cell.
This scanning electron micrograph (courtesy of Dr. Marion J. Barnhart) shows the characteristic biconcave shape of red blood cells.
Thus RBCs are terminally differentiated; that is, they can never divide. They live about 120 days and then are ingested by phagocytic cells in the liver and spleen. Most of the iron in their hemoglobin is reclaimed for reuse. The remainder of the heme portion of the molecule is degraded into bile pigments and excreted by the liver. Some 3 million RBCs die and are scavenged by the liver each second.
Red blood cells are responsible for the transport of oxygen and carbon dioxide.
The hemoglobin (Hb) molecule
- consists of four polypeptides.
- Each of these is attached the prosthetic group heme.
- There is one atom of iron at the center of each heme.
- One molecule of oxygen can bind to each heme.
 The reaction is reversible.
The reaction is reversible.
- Under the conditions of lower temperature, higher pH, and increased oxygen pressure in the capillaries of the lungs, the reaction proceeds to the right. The purple-red deoxygenated hemoglobin of the venous blood becomes the bright-red oxyhemoglobin of the arterial blood.
- Under the conditions of higher temperature, lower pH, and lower oxygen pressure in the tissues, the reverse reaction is promoted and oxyhemoglobin gives up its oxygen.
Carbon Dioxide Transport
Carbon dioxide (CO2) combines with water forming carbonic acid, which dissociates into a hydrogen ion (H+) and a bicarbonate ions:
CO2 + H2O <-> H2CO3 <-> H+ + HCO3-
95% of the CO2 generated in the tissues is carried in the red blood cells:
- About one-half of this is directly bound to hemoglobin (at a site different from the one that binds oxygen).
- The rest is converted - following the equation above - by the enzyme carbonic anhydrase into
- bicarbonate ions that diffuse back out into the plasma and
- hydrogen ions (H+) that bind to the protein portion of the hemoglobin (thus having no effect on pH).
Only about 5% of the CO2 generated in the tissues dissolves directly in the plasma. (A good thing, too: if all the CO2 we make were carried this way, the pH of the blood would drop from its normal 7.4 to an instantly-fatal 4.5!)
When the red cells reach the lungs, these reactions are reversed and CO2 is released to the air of the alveoli.
Anemia is a shortage of
- RBCs and/or
- the amount of hemoglobin in them.
Anemia has many causes. One of the most common is an inadequate intake of iron in the diet.
Blood Groups
Red blood cells have surface antigens that differ between people and that create the so-called blood groups such as the ABO system.
White Blood Cells (leukocytes)
White blood cells
- are much less numerous than red (the ratio between the two is around 1:700),
- have nuclei,
- participate in protecting the body from infection,
- consist of lymphocytes and monocytes with relatively clear cytoplasm, and three types of granulocytes, whose cytoplasm is filled with granules.
There are several kinds of lymphocytes (although they all look alike under the microscope), each with different functions to perform . The most common types of lymphocytes are
- B lymphocytes ("B cells"). These are responsible for making antibodies.
- T lymphocytes ("T cells"). There are several subsets of these:

Although bone marrow is the ultimate source of lymphocytes, the lymphocytes that will become T cells migrate from the bone marrow to the thymus where they mature. Both B cells and T cells also take up residence in lymph nodes, the spleen and other tissues where they
- encounter antigens
- continue to divide by mitosis
- mature into fully functional cells.
Monocytes leave the blood and become macrophages.
This scanning electron micrograph (courtesy of Drs. Jan M. Orenstein and Emma Shelton) shows a single macrophage surrounded by several lymphocytes.
Macrophages are large, phagocytic cells that engulf
- foreign material (antigens) that enter the body
- dead and dying cells of the body.

The most abundant of the WBCs. This photomicrograph shows a single neutrophil surrounded by red blood cells.
Neutrophils squeeze through the capillary walls and into infected tissue where they kill the invaders (e.g., bacteria) and then engulf the remnants by phagocytosis.
This is a never-ending task, even in healthy people: Our throat, nasal passages, and colon harbor vast numbers of bacteria. Most of these are commensals, and do us no harm. But that is because neutrophils keep them in check.
However,
- heavy doses of radiation
- chemotherapy
- and many other forms of stress
can reduce the numbers of neutrophils so that formerly harmless bacteria begin to proliferate. The resulting opportunistic infection can be life-threatening.
The number of eosinophils in the blood is normally quite low (0 - 450/µl). However, their numbers increase sharply in certain diseases, especially infections by parasitic worms. Eosinophils are cytotoxic, releasing the contents of their granules on the invader.
The number of basophils also increases during infection. Basophils leave the blood and develop into mast cells. Their granules contain histamine and when they discharge these are the site of infection, the histamine increases the blood flow to the area.
Mast cells also play an important part in some allergies such as
Platelets and Blood Clotting
Platelets are cell fragments produced from megakaryocytes.
Blood normally contains 150,000 to 450,000 per microliter (µl).
If this value should drop much below 50,000/µl, there is a danger of uncontrolled bleeding. This is because of the essential role that platelets have in blood clotting.
When blood vessels are cut or damaged, the loss of blood from the system must be stopped before shock and possible death occur. This is accomplished by solidification of the blood, a process called coagulation or clotting.
A blood clot consists of
- a plug of platelets enmeshed in a
- network of insoluble fibrin molecules.
Platelet aggregation and fibrin formation both require the proteolytic enzyme thrombin.
Clotting also requires:
- calcium ions (Ca2+)(which is why blood banks use a chelating agent to bind the calcium in donated blood so the blood will not clot in the bag).
- at least a dozen other protein clotting factors. Most of these circulate in the blood as inactive precursors of proteases.
The clotting process
- Damaged cells express a surface protein called tissue factor
- Tissue factor triggers the conversion of inactive clotting factors present in blood into activated ones.
- Each activated clotting factor is a protease that converts still other inactive factors into active ones. Thus what may begin as a tiny, localized event rapidly expands into a cascade of activity.
- The cascade leads to the conversion of inactive prothrombin into thrombin.
- thrombin activates
- platelet aggregation and
- conversion of soluble fibrinogen into an insoluble plug of fibrin.
A deficiency of any one of the clotting factors can lead to uncontrolled bleeding. Most of these conditions are quite rare. The genes are autosomal, and the unlucky patient must inherit two mutant genes to be seriously affected.
However, the genes encoding clotting
- factor VIII (8)
- and factor IX (9)
are on the X chromosome. Thus their inheritance is X-linked.
Males (XY) inherit just a single gene and if this is defective, they will suffer from episodes of uncontrolled bleeding. This ailment is called
- hemophilia A for factor VIII deficiency and
- hemophilia B for factor IX deficiency.
Like most X-linked disorders, hemophilia is found almost exclusively in males.
It turns out that there are many different mutant versions of the genes for factors VIII and IX. Although some produce only a minor effect on the function of their protein, others fail to produce any functioning clotting factor.
What can be done?
Factor VIII and IX can be extracted from donated blood, usually pooled from several thousand donors, and purified. Injections of this material can halt episodes of bleeding in hemophiliacs and have allowed countless young men to live relatively normal lives.
However, in the early 1980s, blood contaminated with the human immunodeficiency virus (HIV) was unknowingly used to manufacture factors VIII and IX. In some areas, 90% or more of the hemophiliacs became infected by these contaminated preparations. Many have since died of AIDS.
The future now looks brighter because:
- all donated blood is now tested to see if the donor has been infected with HIV,
- heating seems to destroy any HIV that might be present,
- recombinant factor VIII and recombinant factor IX made by genetic engineering are now available. And the team that brought us Dolly reports in the 19 December 1997 issue of Science that they have succeeded in cloning female sheep transgenic for the human factor IX gene. The human gene is coupled to the promoter for the ovine (sheep) milk protein beta-lactoglobulin. When the lambs mature, it is hoped that they will secrete large amounts of human factor IX in their milk, which can then be purified for human therapy.
These recombinant factors are made by inserting the DNA encoding the human protein into mammalian cells grown in culture. E. coli cannot be used because these factors are glycoproteins, and E. coli lacks the machinery to attach carbohydrate properly.
It is difficult to see how even the most worried critics of genetic engineering can fail to approve its potential to save the lives of thousands of hemophiliacs in the years to come.
Plasma contains plasminogen, which binds to the fibrin molecules in a clot. Nearby healthy cells release tissue plasminogen activator (TPA), which also binds to fibrin and, as its name suggests, activates plasminogen forming plasmin. Plasmin proceeds to digest fibrin, thus dissolving the clot.
Recombinant human TPA is now produced by recombinant DNA technology. Injected within the first hours after a heart attack, it has saved many lives by dissolving the clot blocking the coronary artery and restoring blood flow before the heart muscle becomes irreversibly damaged.
Plasma is the straw-colored liquid in which the blood cells are suspended.
Composition of blood plasma
| Component | Percent |
|---|
| Water | ~92 |
| Proteins | 6-8 |
| Salts | 0.8 |
| Lipids | 0.6 |
| Glucose (blood sugar) | 0.1 |
Plasma transports materials needed by cells and materials that must be removed from cells:
- various ions (Na+, Ca2+, HCO3-, etc.
- glucose and traces of other sugars
- amino acids
- other organic acids
- cholesterol and other lipids
- hormones
- urea and other wastes
Most of these materials are in transit from a place where they are added to the blood (a "source")
- exchange organs like the intestine
- depots of materials like the liver
to places ("sinks")where they will be removed from the blood.
- every cell
- exchange organs like the kidney, and skin.
Proteins make up 6-8% of the blood.
They are about equally divided between serum albumin and a great variety of serum globulins.
After blood is withdrawn from a vein and allowed to clot, the clot slowly shrinks. As it does so, a clear fluid called serum is squeezed out. Thus:
Serum is blood plasma without fibrinogen and other clotting factors.
 The serum proteins can be separated by electrophoresis.
The serum proteins can be separated by electrophoresis.
- A drop of serum is applied in a band to a thin sheet of supporting material, like paper, that has been soaked in a slightly-alkaline salt solution.
- At pH 8.6, which is commonly used, all the proteins are negatively charged, but some more strongly than others.
- A direct current can flow through the paper because of the conductivity of the buffer with which it is moistened.
- As the current flows, the serum proteins move toward the positive electrode.
- The stronger the negative charge on a protein, the faster it migrates.
- After a time (typically 20 min), the current is turned off and the proteins stained to make them visible (most are otherwise colorless).
- The separated proteins appear as distinct bands.
- The most prominent of these and the one that moves closest to the positive electrode is serum albumin.
- Serum albumin
- is made in the liver
- binds many small molecules for transport through the blood
- helps maintain the osmotic pressure of the blood
- The other proteins are the various serum globulins.
- They migrate in the order
- alpha globulins (e.g., the proteins that transport thyroxine and retinol [vitamin A])
- beta globulins (e.g., the iron-transporting protein transferrin)
- gamma globulins.
- Gamma globulins are the least negatively-charged serum proteins. (They are so weakly charged, in fact, that some are swept in the flow of buffer back toward the negative electrode.)
- Most antibodies are gamma globulins.
- Therefore gamma globulins become more abundant following infections or immunizations.
- Gamma globulins can be harvested from donated blood (usually pooled from several thousand donors) and injected into persons exposed to certain diseases such as chicken pox and hepatitis. Because such preparations of immune globulin contain antibodies against most common infectious diseases, the patient gains temporary protection against the disease.
Because of their relationship to cardiovascular disease, the analysis of serum lipids has become an important health measure.
The table shows the range of typical values as well as the values above (or below) which the subject may be at increased risk of developing atherosclerosis.
| LIPID | Typical values (mg/dl) | Desirable (mg/dl) |
|---|
| Cholesterol (total) | 170-210 | <200 |
| LDL cholesterol | 60-140 | <130 |
| HDL cholesterol | 35-85 | >35 |
| Triglycerides | 40-150 | <135 |
- Total cholesterol is the sum of
- HDL cholesterol
- LDL cholesterol and
- 20% of the triglyceride value
- Note that
- high LDL values are bad, but
- high HDL values are good.
- Using the various values, one can calculate a
cardiac risk ratio = total cholesterol divided by HDL cholesterol
- A cardiac risk ratio greater than 7 is considered a warning.
16 June 1999

 Blood is a liquid tissue. Suspended in the watery plasma are seven types of cells and cell fragments.
Blood is a liquid tissue. Suspended in the watery plasma are seven types of cells and cell fragments.

 The most numerous type in the blood.
The most numerous type in the blood.
 The reaction is reversible.
The reaction is reversible.

The serum proteins can be separated by electrophoresis.
The serum proteins can be separated by electrophoresis.